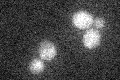
YGL049C
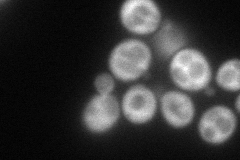
YGL049C
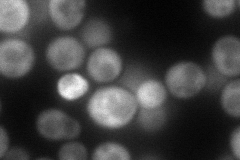
YGL049C
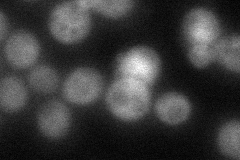
YGL049C
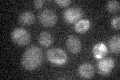
YGL049C

View description
Translation initiation factor eIF4G, subunit of the mRNA cap-binding protein complex (eIF4F) that also contains eIF4E (Cdc33p); associates with the poly(A)-binding protein Pab1p, also interacts with eIF4A (Tif1p); homologous to Tif4631p
Localization:
Intensity:
Fold change:
Significance:
-
C’ GFP library in SD
below threshold14.11 -
N' NOP1pr-GFP in SD
cytosol108.993 -
N' TEF2pr-mCherry in SD
cytosol106.245 -
N' NATIVEpr-GFP in SD
cytosol33.9026 -
N' TEF2pr-VC and Cyto-VN in SD

#N/A0 -
C’ GFP library in SD+DTT

cytosol17.251.22No -
C’ GFP library in SD+H2O2

cytosol15.231.07No -
C’ GFP library in Starvation Media
cytosol17.281.22No -
C’ GFP library on the background of Pup2-DaMP

below threshold -
C’ GFP library on the background of CCT mutant

below threshold15.90991.12686No
